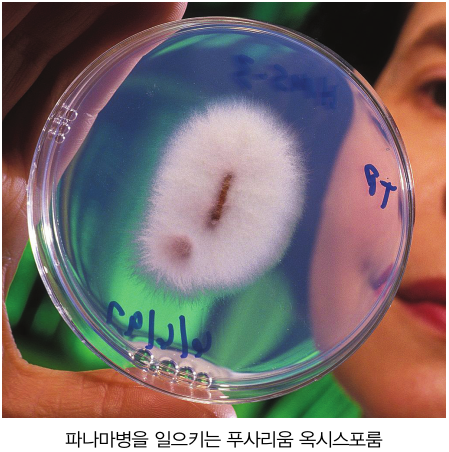

1980년대 이전만 해도 바나나는 비싼 과일이었다. 이제는 ‘흔하디 흔한’ 과일이 된 바나나가 다시 ‘귀하신 몸’이 될지도 모른다.
기획 황진아 기자
달콤하고 부드러운 맛과 저렴한 가격으로 남녀노소 모두에게 사랑받는 바나나. 그러나 얼마 전부터 바나나에 대한 괴담이 흘러나왔다. 바나나가 멸종돼 곧 역사 속으로 사라질 수도 있다는 것. 그 이유는 현재 전세계 바나나시장의 96%를 점유하고 있는 ‘캐번디시 (Cavendish)’종(種)이 ‘바나나 암’이라고 불리는 신종 파나마병에 걸렸기 때문이다.
지금은 캐번디시 바나나가 대부분이지만 사실 1950 년대 이전에 생산되던 바나나는 ‘그로스 미셸(Gross Michel)’이라는 종이었다. 그로스 미셸 바나나는 지금의 바나나에 비해 모양과 향이 다르고 맛과 풍미가 더 좋았다고 한다.
장거리 이동에도 강하고 쉽게 변질되지 않는 등 높은 상품성으로 다국적 기업들은 너도 나도 그로스 미셸 바나나를 재배해 수출했다. 그러나 국가 간 무역이 활발해지며 아시아에서 발생한 파나마병이 중남미로 번졌고, 결국 그로스 미셸 바나나를 멸종시켰다.
식물의 뿌리에 침투해 열매를 맺지 못하게 하고 잎을 시들게 하는 파나마병은 ‘푸사리움 옥시스포룸(Fusarium oxysporum)’이라는 곰팡이로 인해 생긴다. 흙에서 사는 이 곰팡이는 흙 자체가 문제이기 때문에 살균이나 훈증을 통해 방제하기가 어렵다. 영국 캐번디시 공작의 정원사인 조셉 팩스턴(Joseph Paxton)이 발견한 캐번디시 바나나는 파나마병에 강해 그로스 미셸 바나나를 대체하며 현재 연간 5500만톤 이상 생산, 1000억개 이상 소비되고 있다.
그러나 1980년에 처음 발생한 신종 파나마 바이러스인 ‘TR4(Tropocal Race 4)’로 인해 바나나는 또 한 번 위험에 처했다. 그로스 미셸 바나나를 멸종시킨 ‘푸사리움 옥시스포룸’의 생리형(Race)인 TR4는 독성이 매우 강해 신발에 묻은 소량의 흙으로도 전염된다. 캐번디시 바나나는 신종 파나마병에 대한 내성이 거의 없고 전염성이 강해 이미 아프리카와 아시아는 물론 호주까지 전염되며 지금까지 축구장 2000개 크기의 바나나 농장을 오염시켰다.
물론 그렇다고 해서 지금 당장 바나나가 멸종되는 것은 아니다. 그렇지만 현재로서는 신종 파나마병을 막을 방법이 없고, 캐번디시종을 대체할 수 있는 다른 바나나종이 마땅치 않다는 문제가 있다. 신종 파나마병을 견딜 수 있는 종을 만들기까지는 시간이 걸리고, 신종 파나마병 발발 후 지금까지 몇 종류의 다양한 신품종 바나나들이 개발되었거나 개발 중이지만 맛과 품질이 지금의 바나나에 미칠 것인지는 미지수다. 연구자들이 파나마병에 대한 치료제를 개발하고 있지만 이미 퍼진 병을 치료할 수 있을지도 비관적인 상황이라 일부에서는 20년 안에 캐번디시 바나나가 멸종할 것이라는 의견이 나오고 있다.
바나나와 마찬가지로 커피나무도 잎에 감염되는 곰팡이인 ‘헤밀레이아 바스타트릭스 (Hemileia vastatrix)’가 일으키는 ‘커피녹병’으로 고통받고 있다. 이 병에 감염되면 잎 아래 곰팡이가 생기고 땅에 떨어져 결국 생산량이 줄어든다. 다행히 커피녹병은 살균제를 사용하면 피해를 줄일 수 있지만 그에 따른 추가 비용이 들고, 무엇보다 소비자들이 거리낌 없이 받아들일지도 의문이다.

기원전 5000년경부터 말레이 반도에서 재배될 정도로 긴 역사를 가진 바나나는 원래 과육 속에 씨가 가득해 먹기 불편했다. 인간이 먹기 좋게 개량된 오늘날의 바나나는 씨앗이 없어 사람이 가지를 잘라 심어주지 않으면 스스로 번식하지 못한다. 이처럼 다국적 기업에서 상품성이 높은 품종을 대량생산하기 위해 단일 품종화된 상품은 그만큼의 위험성을 가진다. 병에 걸릴 경우 방지하기가 쉽지 않고 환경 변화에 적응하기도 어렵기 때문이다. 개량에 개량을 거듭하며 종의 다양성은 사라지고 대량생산으로 전염병에 취약해진 바나나는 결국 역사 속으로 사라지게 될까?

